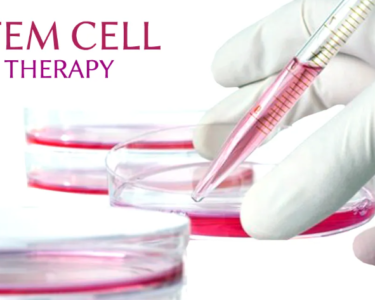

Navigating the academic world can be challenging, especially for UK students who juggle multiple assignments, extracurricular activities, and personal responsibilities. This is where online assignment help services come into play, offering a lifeline to students who need a little extra support. But how do you choose the right service? And how can you ensure that you’re using these services effectively?
In this comprehensive guide, we’ll delve into everything you need to know about online assignment help services in the UK. From understanding what they offer to selecting the best service for your needs, this article will equip you with the knowledge to make informed decisions that can enhance your academic journey.
Understanding Online Assignment Help
What is Online Assignment Help?
Online assignment help is a service provided by professionals to assist students in completing their academic assignments. These services can range from writing essays, reports, and dissertations to providing research and editing support. The primary aim is to help students manage their workload and achieve better academic outcomes.
Key Features of Online Assignment Help Services
- Expert Assistance: Access to professionals with expertise in various subjects.
- Customized Solutions: Tailored content based on the student’s requirements.
- Timely Delivery: Assignments are completed within the stipulated deadlines.
- Plagiarism-Free Content: Assurance of originality and adherence to academic standards.
Benefits of Using Online Assignment Help Services
Time Management and Deadline Adherence
One of the most significant benefits of using online assignment help services is the ability to manage your time more effectively. With the pressure of multiple deadlines, students often find themselves overwhelmed. These services can alleviate that burden by ensuring that assignments are completed on time, allowing students to focus on other important aspects of their academic and personal lives.
Access to Expertise Across Various Subjects
Online assignment help services offer access to experts in a wide range of subjects. Whether you’re struggling with a complex mathematics problem or need help with a literature review, these services can provide you with the specialized knowledge you need to excel.
Improved Academic Performance
By leveraging the expertise of professional writers, students can improve the quality of their assignments, which often leads to better grades. This boost in academic performance can be crucial, especially for those aiming for top marks in their coursework.
Customization and Plagiarism-Free Work
Every student’s needs are different, and online assignment help services recognize this by offering customized solutions. Additionally, they ensure that the work is original and free from plagiarism, which is essential for maintaining academic integrity.
How to Choose the Right Online Assignment Help Service
Identifying Your Academic Needs
Before you start searching for an online assignment help service, it’s crucial to identify your specific academic needs. Are you looking for help with a particular subject, or do you need assistance with multiple assignments? Understanding your requirements will guide you in choosing the right service.
Researching Potential Services
Once you’ve identified your needs, the next step is to research potential services. Look for companies that specialize in your area of study, have a good reputation, and offer the specific services you require.
Evaluating Service Reputation and Reviews
Reputation matters. Take the time to read reviews and testimonials from other students who have used the service. This will give you an idea of the quality of work they provide and whether they are reliable.
Considering Cost and Value for Money
While cost should not be the only factor in your decision, it’s essential to consider whether the service offers good value for money. Compare prices across different services, but also weigh the quality of the work you’re likely to receive.
Top Features to Look for in Online Assignment Help Services
24/7 Customer Support
Having access to customer support at any time of the day is vital. This feature ensures that any questions or concerns you have can be addressed promptly, no matter when they arise.
Qualified and Experienced Writers
The quality of your assignment will largely depend on the expertise of the writer. Ensure that the service employs qualified and experienced writers who are well-versed in your subject area.
Timely Delivery
Deadlines are critical in the academic world. Choose a service that has a proven track record of delivering assignments on time, ensuring that you don’t miss any important submission dates.
Confidentiality and Data Security
Your privacy is important. Make sure that the service you choose guarantees confidentiality and secures your personal information, preventing it from being shared with third parties.
Common Pitfalls to Avoid
Falling for Cheap Prices Without Quality Assurance
While it might be tempting to go for the cheapest option, remember that you often get what you pay for. Low prices can sometimes mean lower-quality work. Always ensure that the service you choose provides quality assurance.
Not Checking for Plagiarism Policies
Plagiarism is a serious offense in academia. Before selecting a service, make sure they have strict plagiarism policies and provide reports to verify the originality of their work.
Ignoring Customer Reviews
Customer reviews offer valuable insights into the reliability and quality of a service. Ignoring these reviews can lead to poor choices. Always take the time to read what other students have to say.
How to Effectively Use Online Assignment Help Services
Communicating Clearly with Your Writer
Effective communication with your writer is crucial for getting the best results. Be clear about your requirements, provide all necessary information, and keep the lines of communication open throughout the process.
Providing Detailed Instructions
The more detailed your instructions, the better the outcome. Ensure that you provide your writer with all the necessary guidelines, including formatting requirements, specific points to cover, and any other relevant details.
Reviewing the Final Work Thoroughly
Once you receive the completed assignment, don’t just submit it immediately. Take the time to review the work thoroughly, check for any errors, and ensure that it meets your expectations.
Legal and Ethical Considerations
Understanding the Ethical Use of Assignment Help
It’s important to use assignment help services ethically. This means using the work as a reference or a guide rather than submitting it as your own. Ethical use of these services can enhance your understanding of the subject matter and improve your academic skills.
The Importance of Academic Integrity
Academic integrity is paramount. Misusing assignment help services can lead to severe consequences, including academic penalties. Always ensure that you maintain honesty and integrity in your academic work.
The Future of Online Assignment Help Services
Innovations and Technological Advancements
The future of online assignment help services is bright, with innovations and technological advancements making these services more accessible and efficient. From AI-driven content creation to personalized learning platforms, the possibilities are endless.
Increasing Integration with Educational Institutions
As online assignment help services continue to grow, there’s a possibility of greater integration with educational institutions. This could lead to more collaborative efforts to support students in their academic journeys.
Conclusion
Navigating online assignment help services can be a game-changer for UK students. By choosing the right service, you can manage your workload more effectively, improve your academic performance, and gain access to expert knowledge. However, it’s crucial to make informed decisions, avoid common pitfalls, and use these services ethically. With the right approach, online assignment help can be a valuable tool in your academic arsenal.
FAQs
- What are Online Assignment Help Services?
Online assignment help services provide students with professional assistance in completing their academic assignments. These services can include writing, research, editing, and more. - Are Online Assignment Help Services Legal?
Yes, online assignment help services are legal. However, it’s important to use them ethically and not to submit purchased work as your own. - How Do I Choose the Best Service for My Needs?
To choose the best service, identify your academic needs, research potential services, evaluate their reputation, and consider the cost and value for money. - What Should I Avoid When Using Assignment Help Services?
Avoid falling for cheap prices without quality assurance, not checking for plagiarism policies, and ignoring customer reviews. - Can I Trust the Quality of Work from Online Services?
Yes, you can trust the quality of work if you choose a reputable service with qualified writers and a track record of delivering high-quality assignments.